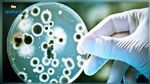
زغوان:  4 إصابات بعدوى شيغالا في صفوف الأطفال

وطنية
وطنية 2022/11/24 19:59
بن قردان: إحباط تهريب ما يناهز 4 أطنان من المواد الغذائية المدعمة
تمكنت دورية تابعة لفرقة الحرس الديواني ببن قردان من ضبط شاحنة تحمل ترقيما تونسيا متجهة إلى إحدى المناطق الحدودية بالجنوب الشرقي محملة بمادة "فيتورة الزيتون"، تم العثور بتفتيشها، تحت المادة المذكورة، على كمية هامة من المواد الغذائية المدعمة (سميد ، كسكسي، مقرونة).
وطنية 2022/11/24 18:27
سعيد: "يتعلّلون بعقود أبرمت تحت جنح الظلام للاستيلاء على أراضي الدولة وآن الأوان لوضع حد لهذه التجاوزات"
استقبل رئيس الجمهورية قيس سعيّد، عصر اليوم الخميس بقصر قرطاج، وزير أملاك الدولة والشؤون العقارية، محمد الرقيق.
وطنية 2022/11/24 18:18
اتفاق بين نقابة أطباء القطاع الخاص و "الكنام"
أمضت النقابة التونسية لأطباء القطاع الخاص والصندوق الوطني للتأمين على المرض، اليوم الخميس، الملحق التعديلي عدد 5 الذي يقضي بتمديد العمل بالاتفاقية القطاعية لمدة 18 شهرا بالإضافة إلى الاتفاق على مراجعة بعض الأعمال الطبية منها التعريفات الجزافية الخاصة بالجراحة والتوليد والتصوير الطبي والطب النووي بداية من غرة ديسمبر المقبل.
وطنية 2022/11/24 17:55
غدا الجمعة.. مفتتح شهر جمادى الأولى
أعلن ديوان الإفتاء للجمهورية التونسية، أن غدا الجمعة 25 نوفمبر 2022، هو مفتتح شهر جُمادى الأولى 1444هجري، وفق بلاغ صادر اليوم الخميس عن ديوان الإفتاء.
وطنية 2022/11/24 17:46
سعيد يشدّد على تسريع الأبحاث في ملف "فاجعة جرجيس"
استقبل رئيس الجمهورية قيس سعيّد، ظهر اليوم الخميس بقصر قرطاج، وزير الداخلية، توفيق شرف الدين، و المدير العام للأمن الوطني، مراد سعيدان.
وطنية 2022/11/24 17:34
أصغر المصابين عمره 6 أشهر وأكبرهم 80 سنة: 96 إصابة بـ"شيغيلا" في تونس
أفادت مديرة رعاية الصحة الأساسية بوزارة الصحة، أحلام قزارة، اليوم الخميس، بأن تونس سجلت 96 حالة تم الاشعار بها أصيبت بجرثومة "شيغيلا"، مضيفة أن الوزارة انطلقت في بحث ميداني لرفع العينات من الأغذية والمياه للتثبت من مصادر الجرثومة.
وطنية 2022/11/24 14:39
زغوان: 4 إصابات بعدوى شيغالا في صفوف الأطفال
أفاد المدير الجهوي للصحة بزغوان الدكتور كريم لحسيني أن 4 أطفال أعمارهم دون الثماني سنوات أصيبوا بعدوى شيغالا بزغوان تم ايواء اثنين منهم بقسم الأطفال بالمستشفى الجهوي بزغوان وآخرين بمستشفى الأطفال بتونس، قبل أن يعودوا جميعا إلى عائلاتهم مع تحسن حالاتهم الصحية.
وطنية 2022/11/24 14:32
مندوب حماية الطفولة يرافق طفلة الأربع سنوات في رحلة عودتها من إيطاليا
أُعلنت وزارة الأسرة والمرأة والطفولة وكبار السنّ أنّ المندوب العام لحماية الطفولة رافق ظهر اليوم الخميس طفلة الأربع سنوات في رحلة عودتها من إيطاليا إلى أرض الوطن وتولى تسليمها إلى أسرتها حال وصولها إلى مطار تونس قرطاج.
وطنية 2022/11/24 12:58
إيقاف نشاط مصنع 'حبوب قرطاج' بزغوان: تداعيات خطيرة على قطاع الأعلاف ومخزون الزيت النباتي
تعتزم ادارة مصنع "حبوب قرطاج " لإنتاج فيتورة وزيت الصوجا بجبل الوسط من ولاية زغوان، إيقاف نشاطه وإحالة العملة على البطالة الفنية خلال الأسابيع القادمة لأسباب اقتصادية، نظرا لارتفاع أسعار المواد الأولية في السوق العالمية، وفق مدير عام المؤسسة ماهر العفاس.
وطنية 2022/11/24 12:44
خميس الجهيناوي يؤكد أهمية الولايات المتحدة في علاقة بالمؤسسات الدولية
قال وزير الشّؤون الخارجية الأسبق خميس الجهيناري إن تونس اليوم مرتبطة بما يحدث من حولها من تطورات في ظل الازمة العالمية التي تشهدها مختلف الدول و تأثيراتها و"مطالبة بأن تكون واعية بجملة القضايا والتحديات والتطورات الدولية للعمل على مجابهتها".
وطنية 2022/11/24 11:58
لأول مرة :انتخاب تونس على رأس المنظمة الدولية للحماية المدنية
انتخب مؤتمر المنظمة الدولية للحماية المدنية، اليوم الخميس، تونس على رأس الجمعية العامة للمنظمة، وذلك لأول مرة منذ تأسيسها.
وطنية 2022/11/24 11:41
محطات لبيع الوقود مهددة بالغلق
قال رئيس اتحاد الصناعة والتجارة والصناعات التقليدية بسوسة ورئيس الغرفة الجهوية لتوزيع المحروقات علي بن يحي، إن الارتفاع المتواصل لأسعار المحروقات، بالتوازي مع ضعف هامش الربح لدى اصحاب محطات بيع البنزين، قد تسبب في مصاعب مالية كبرى يمكن أن تؤدي بعدد كبير منها إلى الإغلاق.
وطنية 2022/11/24 11:25
ندوة حول اجراءات جديدة لتنظيم قطاع الأحذية
في إطار حماية المستهلك التونسي والتشجيع على التصدير والتعريف بالمنتوجات التونسية في مجال صناعة الجلود والأحذية، نظمت اليوم الخميس الجامعة الوطنية للجلود والأحذية بالشراكة مع المركز الوطني للجلود والاحذية مائدة مستديرة للتعريف بالأمر الحكومي عدد 571 لسنة 2020
وطنية 2022/11/24 11:19
بوعسكر :الهيئة تواجه تحديات جديدة في علاقة بمراقبة العملية الانتخابية
أكد فاروق بوعسكر رئيس الهيئة العليا المستقلة للانتخابات أن الهيئة تواجه تحديات جديدة في علاقة بمراقبة العملية الانتخابية وحياد وسائل الإعلام باعتبار أن نظام الاقتراع على الأفراد يفتح المجال للخطاب الدعائي و خطاب العنف والتميز.
وطنية 2022/11/24 10:55
أنشيلوتي يشيد بأداء المنتخب التونسي
أشاد الإيطالي كارلو انشيلوتي، مدرب ريال مدريد الاسباني، بأداء عدد من المنتخبات المشاركة في كأس العالم المقامة في قطر، ومن بينهم المنتخب التونسي.
وطنية 2026/04/24
رياضة 2026/04/24
وطنية 2026/04/21
بداية من الليلة: انقطاع واضطرابات في توزيع المياه بمناطق من المهدية والمنستير
مجتمع 2026/04/24
رياضة 2026/04/22
وطنية 2026/04/24
رئيس الجمهورية: 'قريباً إرساء المجلس الأعلى للتربية والتعليم'